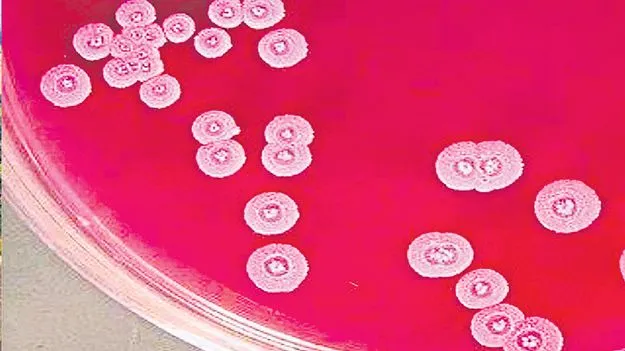
Guntur: అవి మెలియోయిడోసిస్‌ జ్వరాలు

Guntur: అవి మెలియోయిడోసిస్ జ్వరాలు
ABN , Publish Date - Sep 01 , 2025 | 05:00 AM
మిస్టరీ మరణాల గుట్టు వీడింది. గుంటూరు జిల్లా తురకపాలెంలో సంభవించిన వరుస మరణాలకు మెలియోయిడోసిస్ జ్వరాలే కారణమని వైద్యులు తేల్చారు.
బర్కోల్డేరియా సూడోమల్లీ బ్యాక్టీరియానే కారణం
తురకపాలెం మరణాలపై వైద్యుల అభిప్రాయం
‘ఆంధ్రజ్యోతి’ కథనంతో కదిలిన యంత్రాంగం
గుంటూరు మెడికల్, ఆగస్టు 31(ఆంధ్రజ్యోతి): మిస్టరీ మరణాల గుట్టు వీడింది. గుంటూరు జిల్లా తురకపాలెంలో సంభవించిన వరుస మరణాలకు మెలియోయిడోసిస్ జ్వరాలే కారణమని వైద్యులు తేల్చారు. బర్కోల్డేరియా సూడోమల్లీ అనే బ్యాక్టీరియా వల్ల ఈ జ్వరాలు సంభవిస్తాయని చెప్పారు. తురకపాలెం గ్రామంలో విషజ్వరాల బారినపడి 30 మంది మృతిచెందిన విషయంపై ఆదివారం నాటి ‘ఆంధ్రజ్యోతి’ ప్రధాన సంచికలో ‘వరుస మరణాల మిస్టరీ ఏంటి?’ అనే శీర్షికన వార్తాకథనం ప్రచురితమైన సంగతి తెలిసిందే. ఈ కథనం జిల్లా వైద్య వర్గాల్లో తీవ్ర చర్చనీయాంశంగా మారింది. అయితే తురకపాలెంలో పెద్దఎత్తున ప్రబలిన జ్వరాలకు బర్కల్డేరియా సూడోమల్లీ బ్యాక్టీరియానే కారణమని, దీనివల్ల మెలియోయిడోసిస్ జ్వరాలు వస్తాయని ప్రైవేటు వైద్యులు చెప్పారు. ఈ ప్రాంతంలో ఇవి కొత్త జ్వరాలని అన్నారు. దక్షిణాసియా వంటి ఉష్ణ మండల ప్రాంతాల్లో ఈ జ్వరాలు సాధారణంగా కనిపిస్తుంటాయని, ఈ జ్వరం వచ్చిన వెంటనే రోగులు వైద్యనిపుణుల పర్యవేక్షణలో తగిన చికిత్స పొందాలని సూచించారు. ఆలస్యమైతే బ్యాక్టీరియా తీవ్రత వల్ల ఇన్ఫెక్షన్కు గురై వివిధ అవయవాలు దెబ్బతిని మరణించే ప్రమాదం ఉందని తెలిపారు. ఈ బ్యాక్టీరియా మట్టిలో, కలుషిత నీటిలో ఉంటుందని.. ఈ నీళ్లు తాగినా, మట్టిలో చెప్పులు లేకుండా నడిచినా బ్యాక్టీరియా శరీరంలోకి ప్రవేశించి మెలియోయిడోసిస్ జ్వరాలు కలిగిస్తాయని డాక్టర్లు చెప్పారు.
వివిధ అవయవాలు దెబ్బతింటాయి..
తురకపాలెంలో నమోదైన 30 మిస్టరీ మరణాల విషయం ‘ఆంధ్రజ్యోతి’ వెలుగులోకి తెచ్చేంతవరకు తమకు తెలీదని వైద్యవర్గాలు ఆశ్చర్యం వ్యక్తం చేశాయి. కొంతమంది డాక్టర్లు ఫోన్ ద్వారా ‘ఆంధ్రజ్యోతి’తో మాట్లాడారు. పలువురు రోగులు.. జ్వరం, కీళ్ల నొప్పులు, ఆయాసం, కిడ్నీ, కాలేయ సంబంధిత సమస్యలతో తమ దగ్గరకు వచ్చి చికిత్స పొందారని తెలిపారు. బ్లడ్ కల్చర్ పరీక్షల్లో 80 శాతం మందికి బర్కెల్డేరియా సూడోమల్లీ బ్యాక్టీరియా ఇన్ఫెక్షన్ ఉన్నట్లు నివేదికలు వచ్చినట్లు తెలిపారు. బ్యాక్టీరియా తీవ్రత పెరిగి ఇన్ఫెక్షన్ వల్ల వివిధ అవయవాలు దెబ్బతిని వచ్చిన రోగులు చికిత్సలు పొందుతూ ప్రాణాలు కోల్పోయినట్లు వివరించారు. జ్వర ప్రారంభ దశలోనే వచ్చిన రోగులను మాత్రం కాపాడినట్టు వివరించారు. ఇదే జ్వరంతో మృతిచెందిన శౌరి బాబు బ్లడ్ కల్చర్ రిపోర్ట్ను ఆయనకు వైద్యం చేసిన డాక్టర్ కే కల్యాణ్ చక్రవర్తి ‘ఆంధ్రజ్యోతి’కి అందజేశారు. గుంటూరు జిల్లాతో పాటు బాపట్ల, పల్నాడు జిల్లాల నుంచి కూడా మెలియోయిడోసిస్ జ్వర కేసులు గుంటూరులో పలు ప్రైవేటు వైద్యశాలలకు వస్తున్నట్లు తెలిసింది. మధుమేహ బాధితుల్లో తీవ్రత అధికంగా ఉంటున్నట్లు గుర్తించారు.
బ్లడ్ కల్చర్ పరీక్షలో నిర్ధారణ: కల్యాణ్ చక్రవర్తి
తురకపాలెంలో ప్రబలిన మెలియోయిడోసిస్ జ్వరాలకు బర్కోల్డేరియా సూడోమల్లీ అనే బ్యాక్టీరియానే కారణమని గుంటూరులోని ఇన్ఫెక్షియ్స డిసీజెస్ స్పెషలిస్ట్ డాక్టర్ కే కల్యాణ్ చక్రవర్తి చెప్పారు. ‘మెలియోయిడోసిస్ జ్వరం షుగర్, లివర్, కిడ్నీ సంబంధిత దీర్ఘకాలిక వ్యాధులున్న వారిలో ఎక్కువ ప్రభావం చూపుతుంది. జ్వరం, దగ్గు, కీళ్ల నొప్పులు వంటి లక్షణాలతో రోగులు వస్తున్నారు. లక్షణాలు క్షయను పోలి ఉంటాయి. వైద్యపరీక్షల్లో టీబీ కాదని తేలితే మెలియోయిడోసి్సగా అనుమానించాలి. సరైన పద్ధతిలో బ్లడ్ కల్చర్ పరీక్ష ద్వారా మాత్రమే ఇది నిర్ధారణ అవుతుంది. నెల రోజులుగా నలుగురు రోగులు ఈ జ్వరాలతో మా ఆస్పత్రిలో చేరారు. వీరికి రెగ్యులర్ యాంటీబయాటిక్స్ పని చేయవు’ అని ఆయన తెలిపారు.